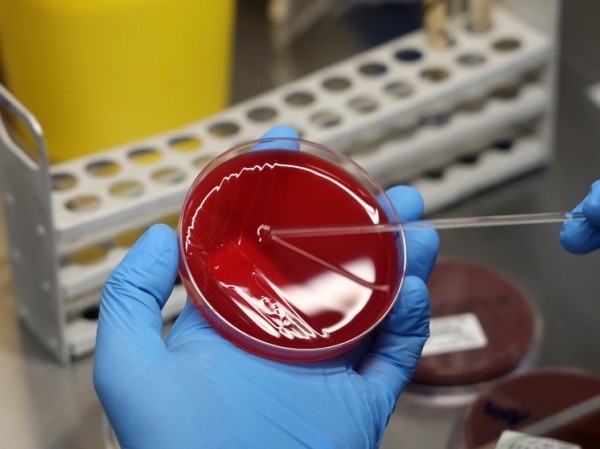
Выявлена способность бактерий во рту «растворять» некоторые виды рака

Выявлена способность бактерий во рту «растворять» некоторые виды рака
«Приводит к улучшению результатов»
Новое исследование показало, что некоторые виды бактерий во рту «растворяют» некоторые виды рака. Считается, что у людей с раком головы и шеи результаты лечения улучшаются, если в их раке обнаруживаются фузобактерии.
Ученые обнаружили, что распространенный тип бактерий во рту может “растворять” некоторые виды рака, пишет The Guardian.
Исследователи из лондонского колледжа Гая, Сент–Томаса и Королевского колледжа Лондона заявили, что были “жестоко удивлены”, обнаружив, что фузобактерии – тип бактерий, обычно встречающихся во рту, — по-видимому, обладают способностью убивать некоторые виды рака.
Согласно результатам исследования, у людей с раком головы и шеи, у которых были обнаружены эти бактерии в раковых клетках, результаты лечения были намного лучше.
В настоящее время исследователи изучают точные биологические механизмы, лежащие в основе этой связи, после получения первоначальных результатов.
Доктор Мигель Рейс Феррейра, старший автор исследования и консультант по раку головы и шеи в больницах Гая и Сент-Томаса, рассказал агентству PA News: “По сути, мы обнаружили, что когда вы обнаруживаете эти бактерии при раке головы и шеи, у них гораздо лучшие результаты. Еще одна вещь, которую мы обнаружили, заключается в том, что в клеточных культурах эта бактерия способна убивать рак. Мы пришли к выводу, что эта маленькая ошибка приводит к улучшению результатов, основываясь на том, что она делает внутри раковой опухоли. Поэтому в настоящее время мы ищем этот механизм, и он должен стать темой для новой статьи в ближайшем будущем”.
Он добавил: “Это исследование показывает, что эти бактерии играют более сложную роль в борьбе с раком, чем было известно ранее, – они, по сути, расплавляют раковые клетки головы и шеи. Однако это открытие следует дополнить их известной ролью в развитии рака, например, в кишечнике”.
Ученые использовали моделирование, чтобы помочь определить, какие бактерии могут представлять интерес для дальнейшего изучения. Затем они изучили влияние бактерий на раковые клетки в лаборатории, а также провели анализ данных о 155 пациентах с раком головы и шеи, информация об опухолях которых была внесена в базу данных Cancer Genome Atlas.
Ученые изначально ожидали другого результата, поскольку предыдущие исследования связывали фузобактерии с прогрессированием рака кишечника, отмечает The Guardian.
В ходе лабораторных исследований исследователи поместили некоторое количество бактерий в чашки Петри и оставили их на пару дней. Когда они вернулись, чтобы проверить влияние бактерий на рак, они обнаружили, что рак почти исчез.
Исследователи обнаружили, что после заражения фузобактериями количество жизнеспособных раковых клеток в клетках рака головы и шеи сократилось на 70-99%.
Анализ данных пациентов показал, что те, у кого были обнаружены фузобактерии в раковой опухоли, имели лучшие шансы на выживание по сравнению с теми, у кого их не было. Обнаружение фузобактерий при раке головы и шеи было связано со снижением риска смерти на 65% по сравнению с пациентами, у которых рак не содержал этих бактерий.
Исследователи надеются, что это открытие поможет в лечении пациентов с раком головы и шеи, который включает в себя рак полости рта, горла, голосовых связок, носа и придаточных пазух носа.
Эксперты заявили, что за последние 20 лет в лечении рака головы и шеи было достигнуто мало успехов, поэтому есть надежда, что это открытие может привести к появлению новых методов лечения в будущем, подчеркивает The Guardian.
Рейс Феррейра сказал, что до начала лабораторной работы команда ожидала, что фузобактерия будет стимулировать рост этих видов рака или сделает их более устойчивыми к лучевой терапии. Но на самом деле они обнаружили, что “через несколько дней она просто полностью уничтожает рак”.
“Вы вводите ее в раковые клетки в очень малых количествах, и она просто начинает убивать их очень быстро”, — сказал он.
Доктор Анджали Чандер, старший научный сотрудник Королевского колледжа Лондона и ведущий автор исследования, сказала: “Наши результаты замечательны и очень удивительны. Мы были поражены, когда обнаружили, что наши зарубежные коллеги также нашли данные, подтверждающие это открытие”.
Барбара Касуму, исполнительный директор благотворительной организации Guy’s Cancer Charity, которая помогла профинансировать исследование, сказала: “Мы гордимся тем, что поддерживаем новаторское исследование, проведенное Мигелем и Анджали, целью которого является углубление нашего понимания рака головы и шеи и разработка более сострадательных и эффективных методов лечения”.
Источник: www.mk.ru

Комментарии закрыты.